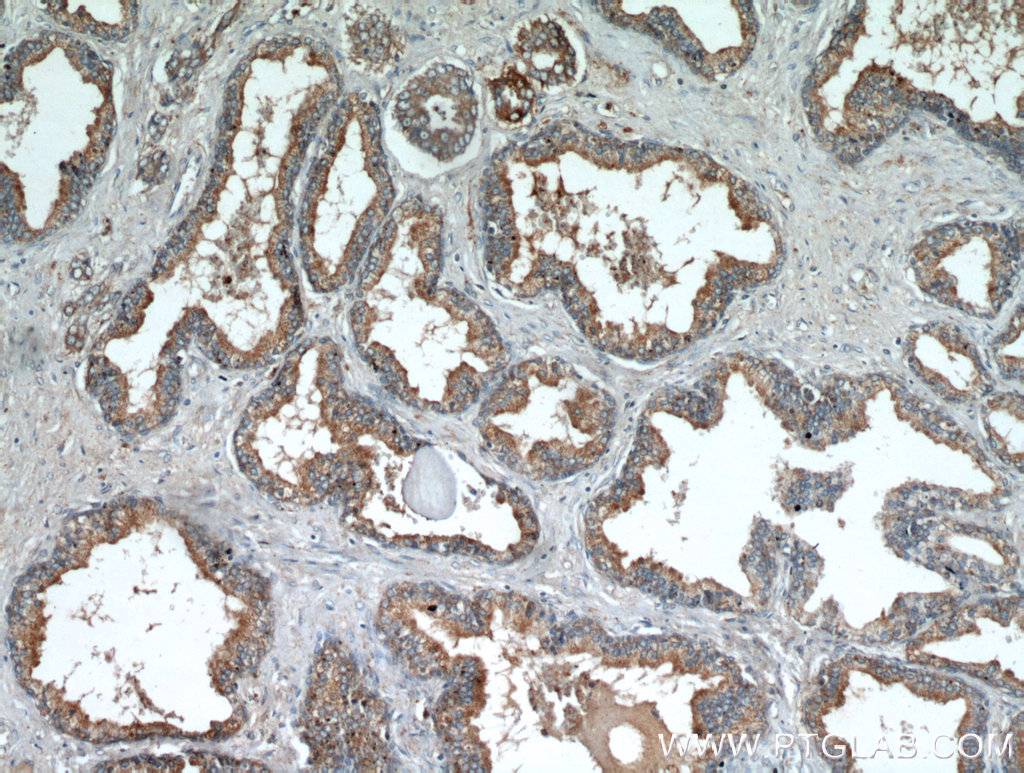
产品细节图片3
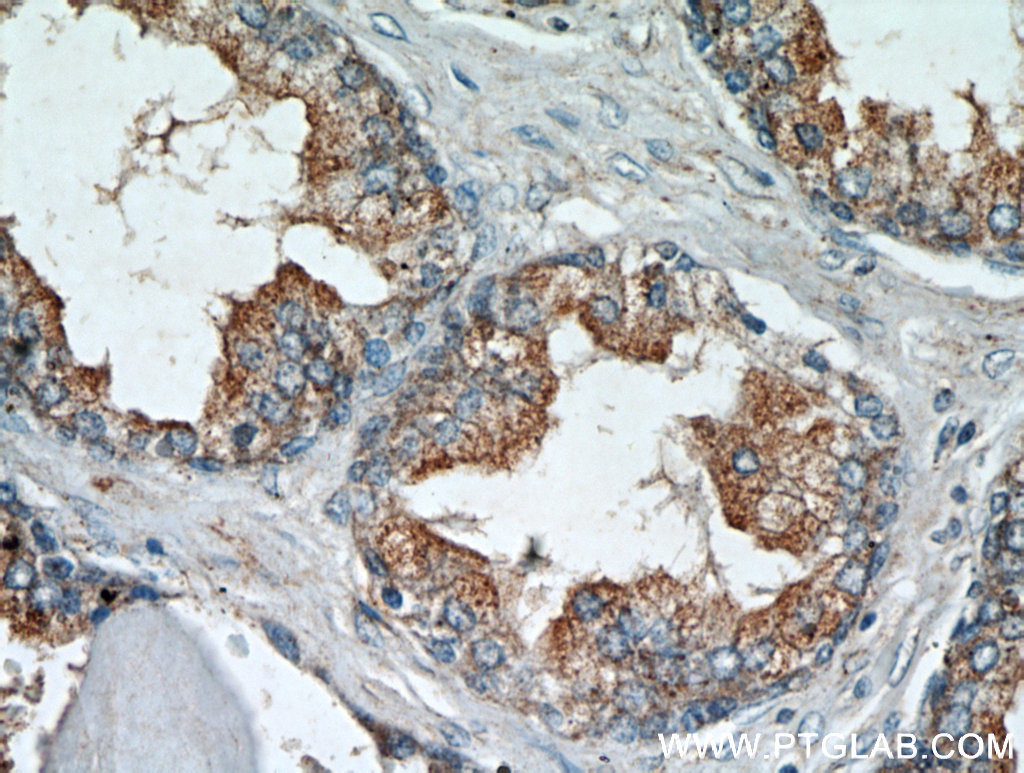
产品细节图片4

相关产品推荐更多 >
万千商家帮你免费找货
0 人在求购买到急需产品
- 详细信息
- 询价记录
- 文献和实验
- 技术资料
- 抗体英文名:
Anti-Leptin receptor(long)
- 应用范围:
IHC/WB/ELISA
- 适应物种:
人,小鼠
- 抗原来源:
Rabbit
- 保质期:
一年
- 库存:
大量
- 供应商:
上海研卉生物科技有限公司
- 是否单克隆:
多克隆
- 保存条件:
低温
- 规格:
50ul
In-house applications ELISA, IHC, IF, WB, IP, FC
Published applications IHC, WB
Species specificity Human, Mouse; other species not tested.
Published Species human
Positive WB detected in
| mouse heart tissue, PC-3 cells | |||
| Positive IP detected in | mouse heart tissue | ||
| Positive IHC detected in | human prostate hyperplasia tissue, human heart tissue | ||
| Positive IF detected in | MCF-7 cells | ||
| Positive FC detected in | HeLa cells | ||
| Recommended dilution | WB : 1:500-1:5000 IP : 1:200-1:2000 IHC : 1:50-1:200 IF : 1:10-1:100 |
||
IP = Immunoprecipitation
Synonyms CD295, DB, HuB219, LEP R, LEPR, leptin receptor, OB R, OB receptor, OBR

风险提示:丁香通仅作为第三方平台,为商家信息发布提供平台空间。用户咨询产品时请注意保护个人信息及财产安全,合理判断,谨慎选购商品,商家和用户对交易行为负责。对于医疗器械类产品,请先查证核实企业经营资质和医疗器械产品注册证情况。
- 作者
- 内容
- 询问日期
 文献和实验
文献和实验趁年轻,动起来:Nature 报道运动促进骨髓产生免疫细胞,但这种能力随年龄增长而消失
niche)。而 HSPCs 又负责生产血细胞系,包括免疫细胞 [3]。 在小鼠中,一些间质祖细胞产生一种被称为干细胞因子(stem cell factor,SCF)的信号分子,对 HSPCs 维持起到关键作用 [4]。这些细胞同时表达一种细胞表面蛋白,瘦素受体蛋白(Leptin Receptor,LepR)。这群 LepR+ 细胞在包括两种类型的血管、小动脉和血窦等完全不同的位置都有存留。然而,LepR+ 细胞群是由多种基质祖细胞组成的混合细胞群,哪些细胞是真正在维持 HSPC 微环境中起作用
温度感受器 thermal receptor,thermoreceptor
为温度刺激的感受器,是温度觉的媒介者。主要被认为是属于皮肤感受器,但确实得到鉴定的还不多。节肢动物,是指把突起伸向表皮细孔中的初级感觉细胞,但其它动物,通常是指皮肤内的游离神经末梢。对于人类,卢芬尼小体( Ruffini’ s body)被认为是温感受器( warmth receptor)或是温器官(德 W rmeorgan),而克劳斯( Krause)小体(球状小体)则被认为是冷感受器( cold receptor)或冷器官(德 Klteorgan)。前者形大,呈树枝状分布的游离
The 1,4-benzodiazepines have become the most frequently prescribed of all psychotropic drugs since the introduction of the first member of this series, chlordiazepoxide, into clinical practice in 1960. The compounds are used as anxiolytics
 技术资料
技术资料暂无技术资料 索取技术资料










